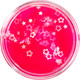
Миниатюра изображения товара Слайм Genio Kids Мялка-жмялка / LIZ51

Слайм Genio Kids Мялка-жмялка / LIZ51

Возраст
от 12 до 18 лет
Вид слайма
с шариками/посыпкой
Особенность
антистресс
Вес
50 г
Цвет товара зависит от партии поставки.
Основные
- Тип
- слайм
- Вид слайма
- с шариками/посыпкой
- Особенность
- антистресс
- Коллекция
- Мялка-жмялка (Genio Kids)
- Цвет
- зависит от партии поставки (голубой, розовый, полупрозрачный, зеленый)
- Возраст
- от 12 до 18 лет
- Упаковка
- баночка
Размеры и вес
- Вес
- 50 г
Страна производства: Беларусь
Производитель: Группа Компаний «Создатели мечты», Республика Беларусь, 220141 г. Минск, ул. Ф. Скорины-52 (кор.III-7, ком.1), Беларусь
Поставщик: СООО "ВОЛШЕБНЫЙ ОСТРОВ", Республика Беларусь, 222827, Минская обл., Пуховичский р-н,г. Марьина Горка, ул. Новая Заря, д. 49, комн. 2
Производители оставляют за собой право изменять внешний вид, характеристики и комплектацию товара, предварительно не уведомляя продавцов и потребителей. Просим вас отнестись с пониманием к данному факту и заранее приносим извинения за возможные неточности в описании и фотографиях товара. Будем благодарны вам за — это поможет сделать наш каталог еще точнее!












